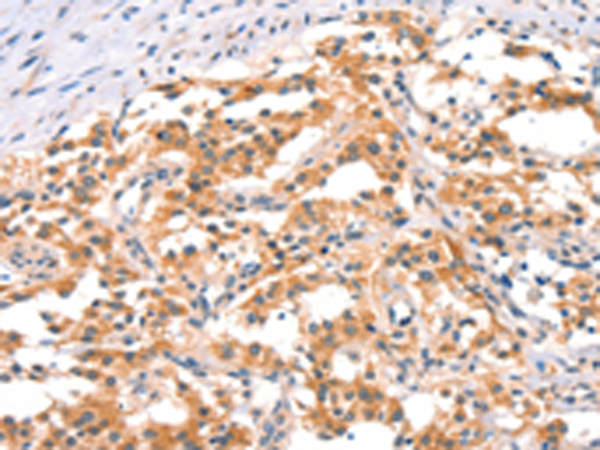

標 記 物: Unconjugate
技術規格
Background:
The protein encoded by this gene phosphorylates the inhibitor in the inhibitor/NF-kappa-B complex, causing dissociation of the inhibitor and activation of NF-kappa-B. The encoded protein itself is found in a complex of proteins. Several transcript variants, some protein-coding and some not, have been found for this gene.
Applications:
ELISA, IHC
Name of antibody:
IKBKB
Immunogen:
Synthetic peptide of human IKBKB
Full name:
inhibitor of kappa light polypeptide gene enhancer in B-cells, kinase beta
Synonyms:
IKK2; IKKB; NFKBIKB; IKK-beta
SwissProt:
O14920
ELISA Recommended dilution:
1000-2000
IHC positive control:
Human thyroid cancer and Human gastric cancer
IHC Recommend dilution:
25-100
購物車
購物車 幫助
幫助
 021-54845833/15800441009
021-54845833/15800441009
